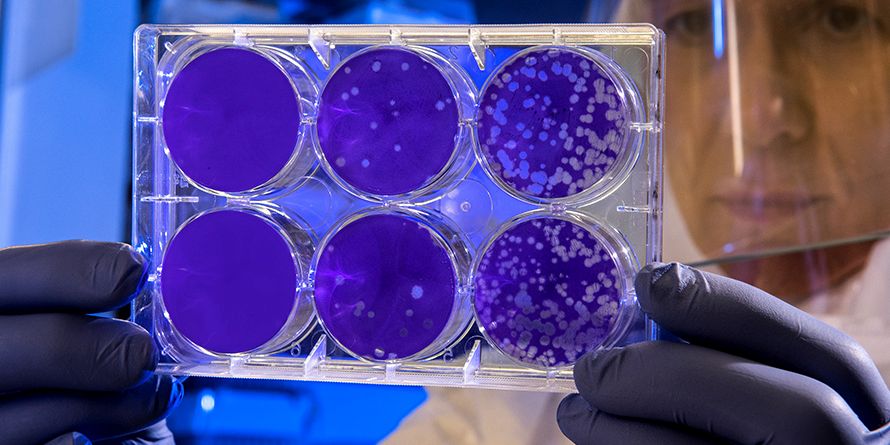
img-Shows-postponed

Coronavirus fears lead to postponement of Dscoop, Sign and Digital UK and ISA Sign Expo
Conferences, festivals and sporting events around the globe are being cancelled or postponed as the coronavirus continues to spread. Notifications of postponement were received this week from international industry shows Dscoop, Sign and Digital UK and ISA Sign Expo.
“Dscoop has been closely monitoring the latest information regarding COVID-19. To protect the well-being of our attendees, partners, speakers, and employees, the Dscoop global Board — comprised of HP executives, Dscoop PSP members, and Dscoop leadership — has decided to reschedule Edge Orlando 2020 to a later date, still to be determined. We will keep you updated as soon as possible,” said Dscoop in a statement.
Sign & Digital was to be held at the NEC in Birmingham at the end of April but has now been postponed until next March, while the ISA Sign Expo (Orange County Convention Center) has been postponed until 23 – 25 August 2020, with preconference sessions on 22 August 2020.
“The ISA Board believes that rescheduling ISA Sign Expo provides the most viable solution to bring the entire sign, graphics and visual communication industry to come together to get business done,” said the show organisers on www.signexpo.org.




